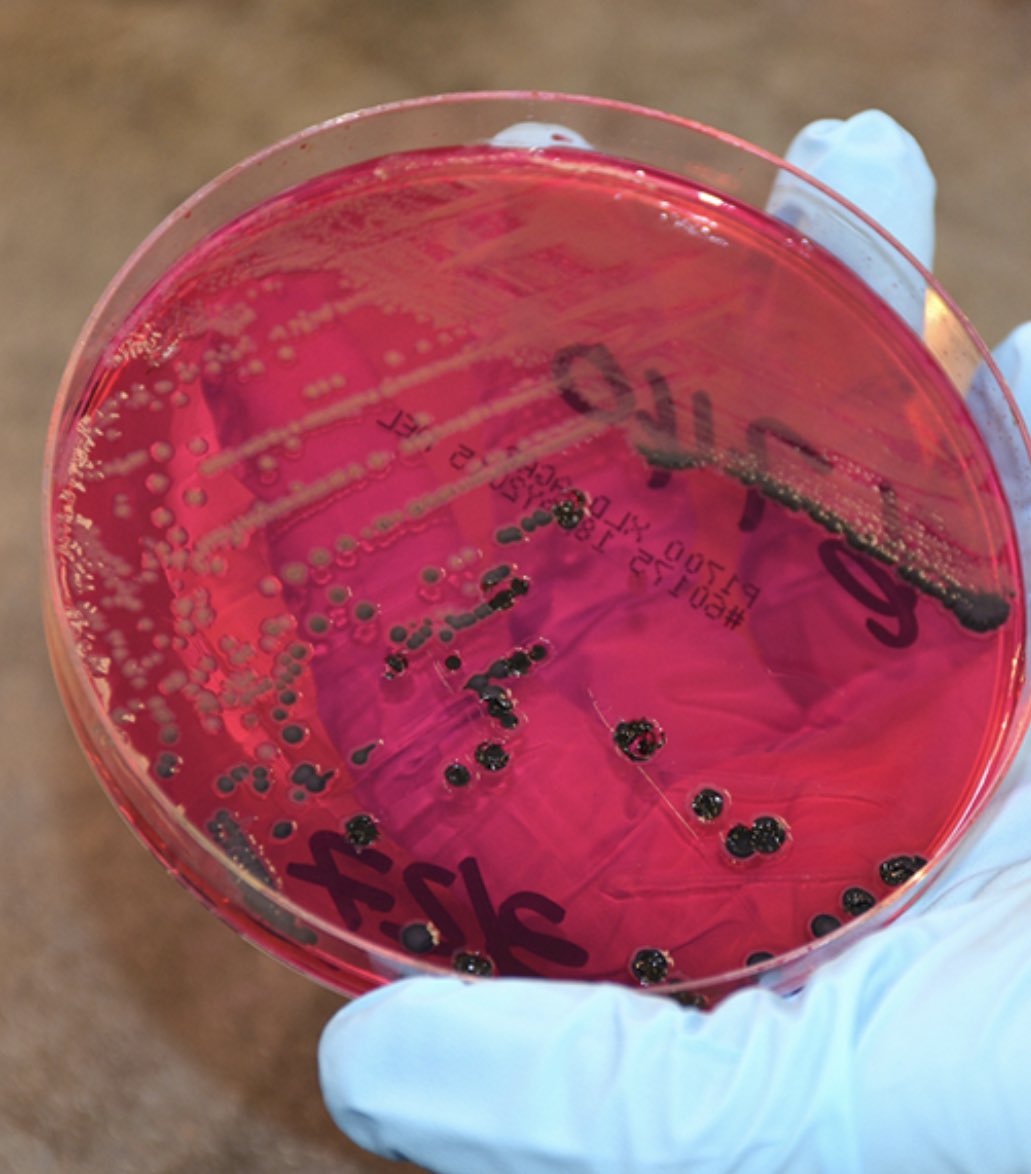

حويصلتها الصفراوية دون ان تصاب هي نفسها بداء التايفويد وتعود شهرتها لانها كانت تنتقل من منزل الى اخر وما ان تبدا عملها في طهي الطعام حتى يبدا افراد الاسرة في الوفاة واحدا تلو الاخر وبعد الكثير من التحقيقات و التحاليل تبين انها كانت حاملة للبكتريا في جسدها
تم عزل ماري في جزيرة
تم عزل ماري في جزيرة
بمفردها تبعد 18 ميلا عن شاطئ الولايات المتحدة حتى صدر قرار بمنع عزل حاملي الامراض وتم الافراج عنها بشرط ان لا تباشر مهنة الطهي ولكنها عادت لتعمل كطاهية في مستشفى ريفي باوراق واسماء مزورة وعندما عادت الحالات للظهور مرة اخرى تم اكتشافها واحيلت للقضاء هذه المرة
جاري تحميل الاقتراحات...